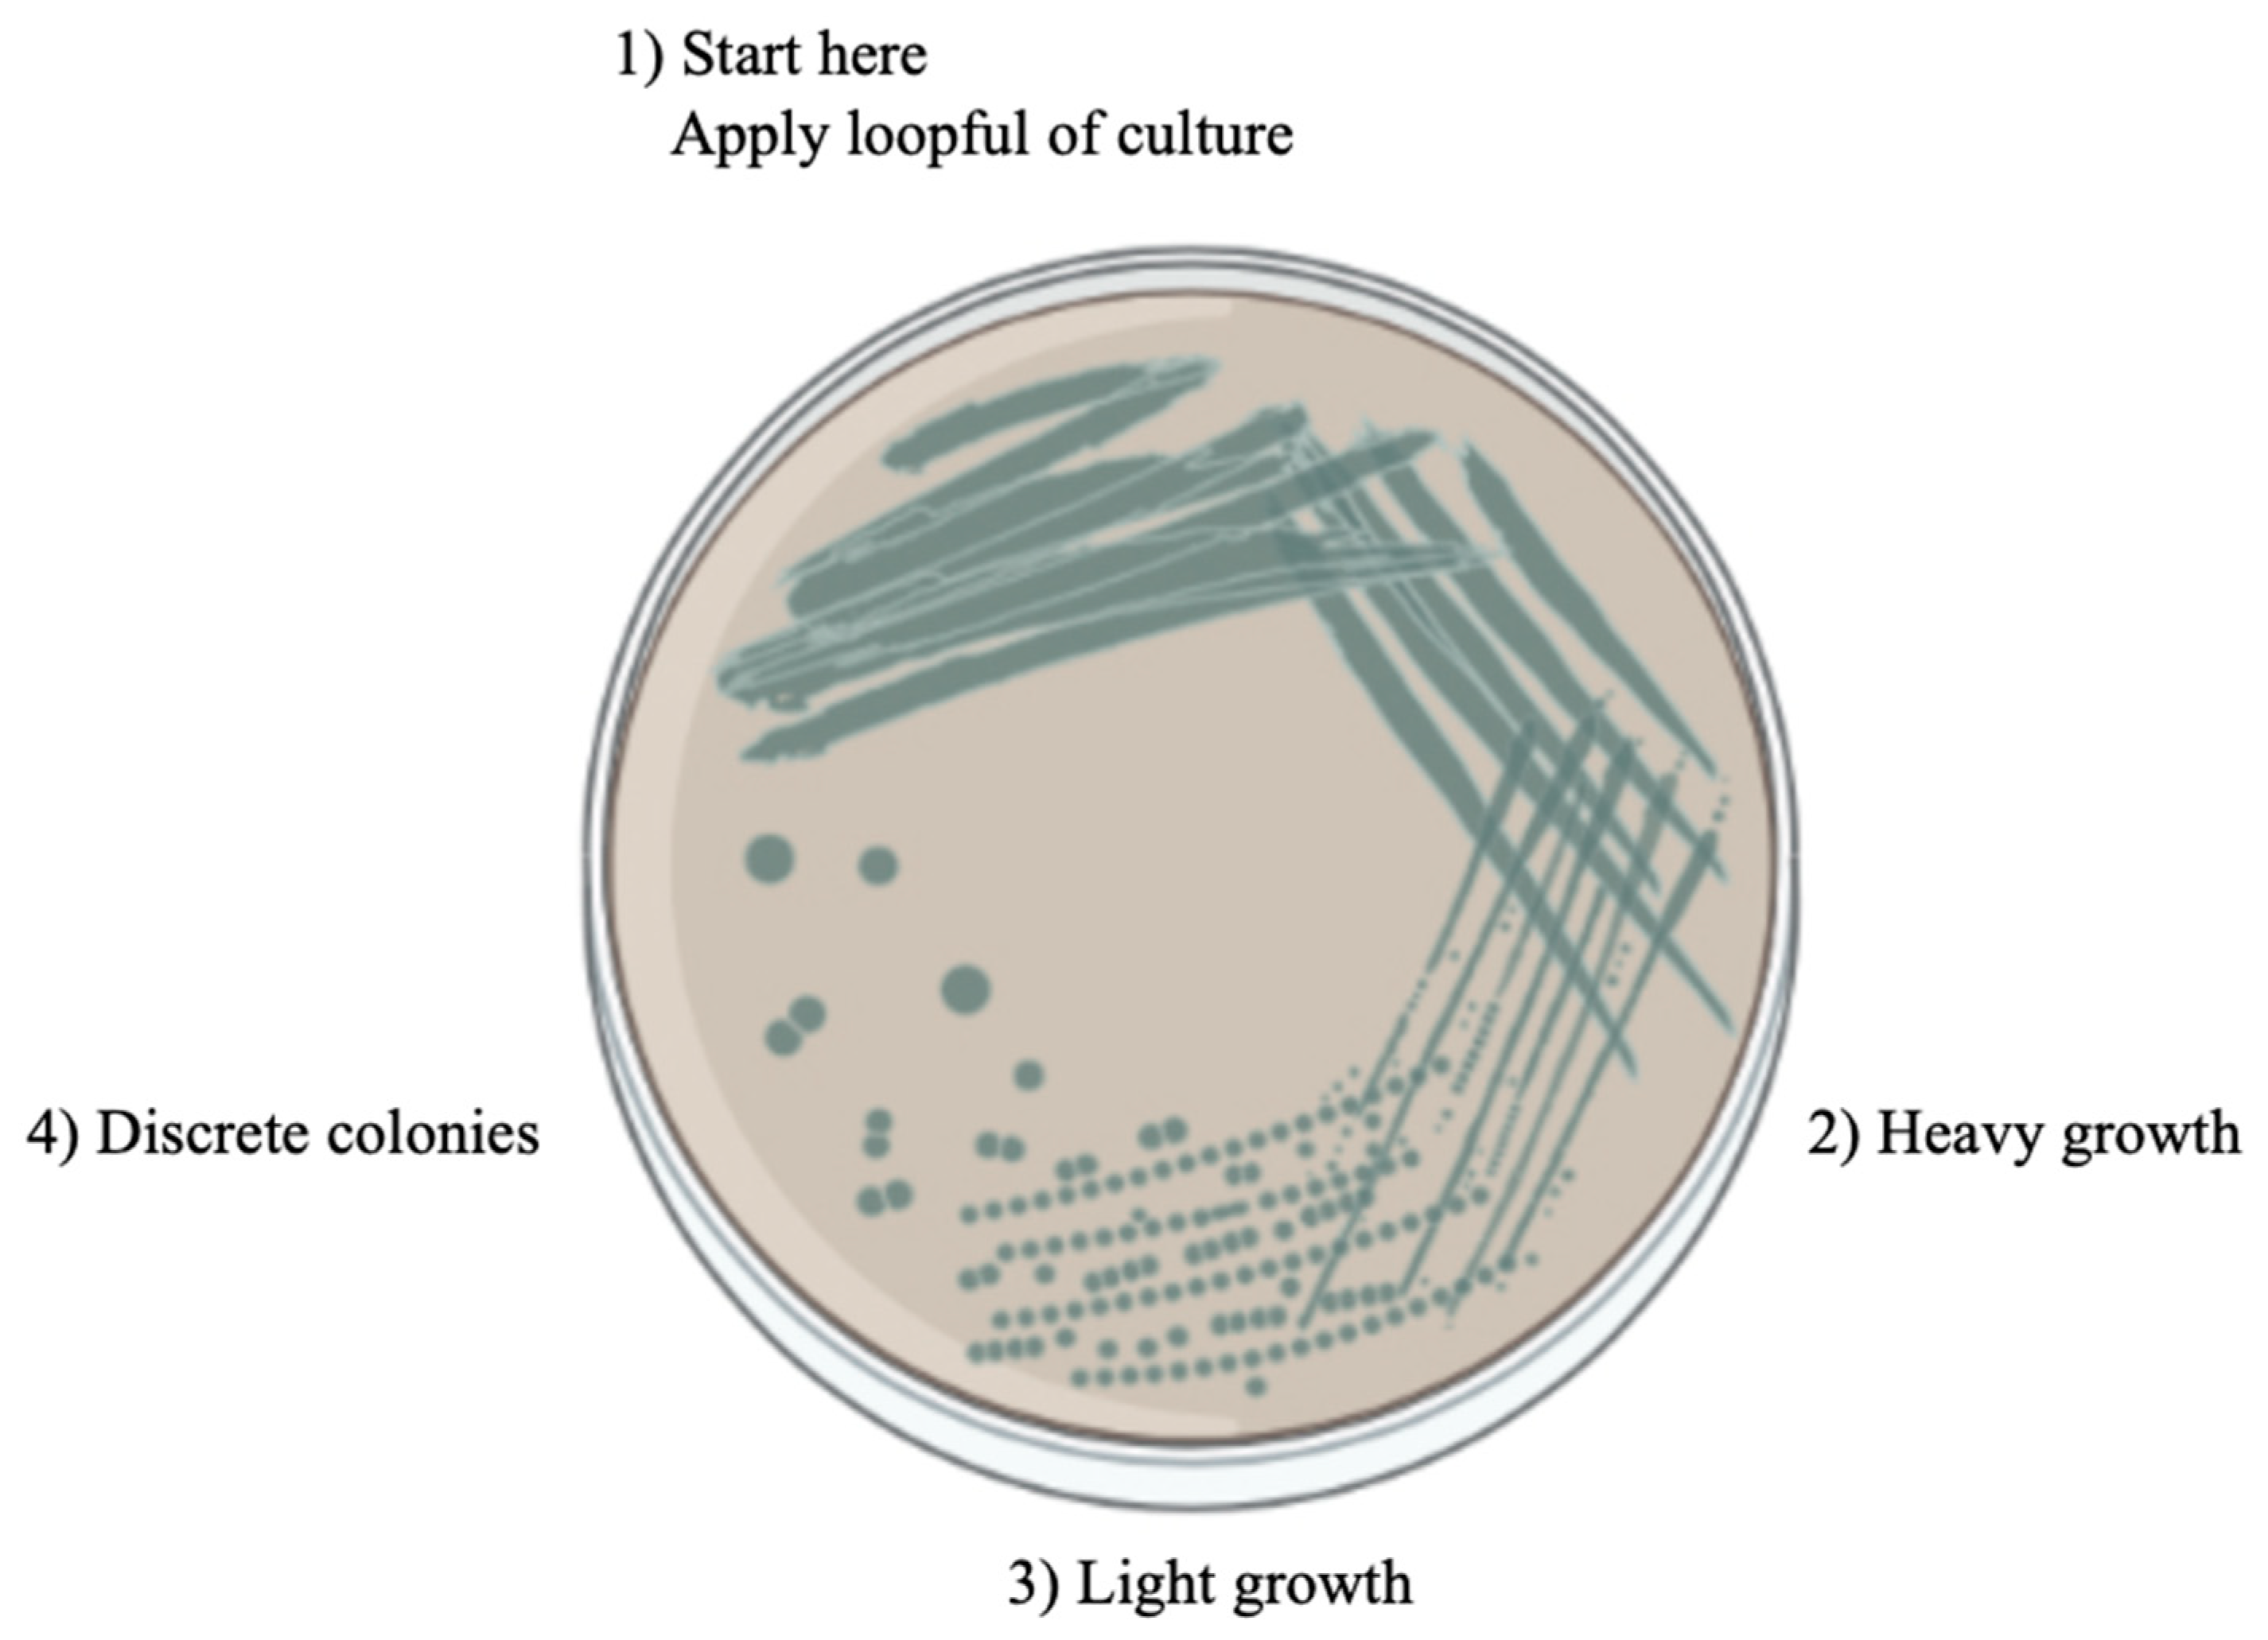
Metals 13 01974 g006

Effect of Acetate on Microbiologically Influenced Corrosion of Internal Pipeline Surfaces
Abstract
:1. Introduction
2. Experimental Details
2.1. Material
2.2. Test Matrix and Solution Preparation
2.2.1. Preparation of Formation Water
2.2.2. Preparation of Postgate Medium B (PMB) Solution
2.2.3. Preparation of Acetate Buffer
2.2.4. Isolation and Detection of SRB Using SRB-Bart Kit
2.2.5. Serial Dilution and Plating for SRB
2.2.6. Streak Plate Method for Pure Culture
2.3. Corrosion Measurement
2.3.1. Linear Polarization Resistance test
- Rp: polarization resistance (Ohm);
- ∆E: potential difference (V);
- ∆I: change in current (A).

| Description | |
|---|---|
| Size of Sample | 10 mm × 10 mm × 5 mm |
| Counter electrode | Stainless steel |
| Reference electrode | Silver/silver chloride (Ag/AgCl) |
| Working electrode | Carbon steel A283 Grade C |
- icorr: corrosion current density, A.cm−2;
- B: Stern–Geary constant.
- CR: corrosion rate, mm/yr;
- M/n: equivalent weight, gm;
- P: density of metal.
2.3.2. Weight Loss Immersion Test
- CR = corrosion rate (mm/year);
- ∆w = weight loss (g);
- A = exposed surface area of coupon (cm2);
- ρ = density of carbon steel (g/cm3);
- T = time (hours);
- k: constant for unit conversion (8.76 × 104).

2.4. Surface Characterization of Carbon Steel
3. Results
3.1. Corrosion Rate under Simulated Formation Water in Saturated CO2: Case A
3.2. SEM Images and EDX Results: Case A
3.3. Corrosion Rate under Simulated Formation Water and Postgate Medium B in Saturated CO2: Case B
3.4. SEM Images and EDX Results: Case B
4. Discussion
5. Conclusions
- (i)
- The presence of acetate in the medium enhanced the metabolism of SRB and resulted in more pronounced corrosion of the surface of carbon steel.
- (ii)
- Without SRB, adding acetate reduced the corrosion rate.
- (iii)
- The pitting and sulphur deposit on the surface of carbon steel indicates that H2S is a byproduct of SRB metabolism and reacts with the carbon steel surface to form FeS.
- (iv)
- More sulphur deposit was detected in PMB media, resulting in severe pitting on the carbon steel surface.
- (v)
- FeS formation can lead to the deposition of corrosion products on the layer of the carbon steel surface, which can further accelerate corrosion by allowing the penetration of a corrosive agent into the carbon steel substrate.
- (vi)
- The mechanism of pitting corrosion is due to the anaerobic respiration of SRB utilizing acetate through biochemical reactions in the bacteria cell.
- (vii)
- SRB use acetate as an electron donor and sulphate as an electron acceptor, converting them into H2S and CO2 as end products. This reaction provides energy for the SRB to grow and carry out their metabolic activities.
Author Contributions
Funding
Institutional Review Board Statement
Informed Consent Statement
Data Availability Statement
Conflicts of Interest
References
- Little, B.J.; Lee, J.S. Microbiologically Influenced Corrosion. In Kirk-Othmer Encyclopedia of Chemical Technology; Hoboken, N.J., Ed.; John Wiley & Sons, Inc.: Hoboken, NJ, USA, 2009. [Google Scholar] [CrossRef]
- Liu, T.; Cheng, Y.F.; Sharma, M.; Voordouw, G. Effect of fluid flow on biofilm formation and microbiologically influenced corrosion of pipelines in oilfield produced water. J. Pet. Sci. Eng. 2017, 156, 451–459. [Google Scholar] [CrossRef]
- Rebak, R.B.; Perez, T.E. Effect of carbon dioxide and hydrogen sulfide on the localized corrosion of carbon steels and corrosion resistant alloys. In CORROSION 2017; OnePetro: Richardson, TX, USA, 2017. [Google Scholar]
- Yazdi, M.; Khan, F.; Abbassi, R.; Quddus, N.; Castaneda-Lopez, H. A review of risk-based decision-making models for microbiologically influenced corrosion (MIC) in offshore pipelines. Reliab. Eng. Syst. Saf. 2022, 223, 108474. [Google Scholar] [CrossRef]
- Emmanuel, J.I.; Shaapere, T.T. Sulphate Reducing Bacteria SRB Control and Risk Based SRB Severity Ranking. In Abu Dhabi International Petroleum Exhibition & Conference; OnePetro: Richardson, TX, USA, 2018. [Google Scholar] [CrossRef]
- Houghton, J.; Fike, D.; Druschel, G.; Orphan, V.; Hoehler, T.M.; Marais, D.J.D. Spatial variability in photosynthetic and heterotrophic activity drives localized δ13Corg fluctuations and carbonate precipitation in hypersaline microbial mats. Geobiology 2014, 12, 557–574. [Google Scholar] [CrossRef]
- Little, B.J.; Lee, J.S. Microbiologically influenced corrosion. In Oil and Gas Pipelines; Wiley Online Library: New York, NY, USA, 2015; pp. 387–398. [Google Scholar]
- Van Aalst, J.A.; Isakov, R.; Polk, J.D.; Van Antwerp, A.D.; Yang, M.; Fratianne, R.B. Hydrogen sulfide inhalation injury. J. Burn Care Rehabil. 2000, 21, 248–253. [Google Scholar] [CrossRef] [PubMed]
- Thomas, C.J.; Edyvean, R.G.J.; Brook, R. Biologically enhanced corrosion fatigue. Biofouling 1988, 1, 65–77. [Google Scholar] [CrossRef]
- Cord-Ruwisch, R. Microbially Influenced Corrosion of Steel. In Environmental Microbe-Metal Interactions; Wiley Online Library: New York, NY, USA, 2000; pp. 159–173. [Google Scholar] [CrossRef]
- Reis, M.A.M.; Almeida, J.S.; Lemos, P.C.; Carrondo, M.J.T. Effect of hydrogen sulfide on growth of sulfate reducing bacteria. Biotechnol. Bioeng. 1992, 40, 593–600. [Google Scholar] [CrossRef]
- Hasnain, S.; Pirzada, S.H.A. Corrosion in oil and gas Industries: A review. ResearchGate. 2022. Available online: https://www.researchgate.net/publication/365650732_Corrosion_in_Oil_and_Gas_Industries_A_Review (accessed on 28 June 2023).
- Georgiadis, A.G.; Charisiou, N.; Yentekakis, I.V.; Goula, M.A. Hydrogen sulfide (H2S) removal via MOFs. Materials 2020, 13, 3640. [Google Scholar] [CrossRef]
- Cahn, R.S.; Dermer, O.C. Introduction to Chemical Nomenclature; Butterworth-Heinemann: Oxford, UK, 2013. [Google Scholar]
- Zhang, X.; Zhou, S.; Leonik, F.M.; Wang, L.; Kuroda, D.G. Quantum mechanical effects in acid–base chemistry. Chem. Sci. 2022, 13, 6998–7006. [Google Scholar] [CrossRef]
- Bhaduri, D.; Mandal, A.; Chakraborty, K.; Chatterjee, D.; Dey, R. Interlinked chemical-biological processes in anoxic waterlogged soil—A review. Indian J. Agric. Sci. 2017, 87, 1587–1599. [Google Scholar] [CrossRef]
- Sand, W. Microbial mechanisms of deterioration of inorganic substrates—A general mechanistic overview. Int. Biodeterior. Biodegrad. 1997, 40, 183–190. [Google Scholar] [CrossRef]
- Ohaeri, E.; Eduok, U.; Szpunar, J. Hydrogen related degradation in pipeline steel: A review. Int. J. Hydrog. Energy 2018, 43, 14584–14617. [Google Scholar] [CrossRef]
- AlAbbas, F.M.; Kakpovbia, A.; Olson, D.L.; Mishra, B.; Spear, J.R. The Role of Bacterial Attachment to Metal Substrate and Its Effects on Microbiologically Influenced Corrosion (MIC) in Transporting Hydrocarbon Pipelines. J. Pipeline Eng. 2012, 11, 131–144. [Google Scholar] [CrossRef]
- Kushkevych, I.; Dordević, D.; Vítězová, M. Possible synergy effect of hydrogen sulfide and acetate produced by sulfate-reducing bacteria on inflammatory bowel disease development. J. Adv. Res. 2021, 27, 71–78. [Google Scholar] [CrossRef]
- Colleran, E.; Finnegan, S.; Lens, P. Anaerobic treatment of sulphate-containing waste streams. Antonie Van Leeuwenhoek 1995, 67, 29–46. [Google Scholar] [CrossRef]
- Odom, J.M.; Peck, H.D., Jr. Hydrogenase, electron-transfer proteins, and energy coupling in the sulfate-reducing bacteria Desulfovibrio. Annu. Rev. Microbiol. 1984, 38, 551–592. [Google Scholar] [CrossRef] [PubMed]
- Selig, M.; Schäfer, T.; Schönheit, P. Acetyl-CoA synthetase (ADP forming) in archaea, a novel enzyme involved in acetate formation and ATP synthesis. Arch. Microbiol. 1993, 159, 72–83. [Google Scholar] [CrossRef]
- Bose, S.; Ramesh, V.; Locasale, J.W. Acetate metabolism in physiology, cancer, and beyond. Trends Cell Biol. 2019, 29, 695–703. [Google Scholar] [CrossRef]
- Ling, R.; Chen, G.; Tang, X.; Liu, N.; Zhou, Y.; Chen, D. Acetyl-CoA synthetase 2 (ACSS2): A review with a focus on metabolism and tumor development. Discov. Oncol. 2022, 13, 58. [Google Scholar] [CrossRef]
- Pike, L.; Smift, A.; Croteau, N.J.; Ferrick, D.A.; Wu, M. Inhibition of fatty acid oxidation by etomoxir impairs NADPH production and increases reactive oxygen species resulting in ATP depletion and cell death in human glioblastoma cells. Biochim. Et Biophys. Acta Bioenerg. 2011, 1807, 726–734. [Google Scholar] [CrossRef]
- Cao, J.; Zhang, G.; Mao, Z.-S.; Li, Y.; Fang, Z.; Yang, C. Influence of electron donors on the growth and activity of sulfate-reducing bacteria. Int. J. Miner. Process. 2012, 106, 58–64. [Google Scholar] [CrossRef]
- Farhat, H. A Case Study of Soil-Side Corrosion of Aboveground Storage Tanks in the Middle East. In CORROSION 2018; OnePetro: Richardson, TX, USA, 2018. [Google Scholar]
- Sar, M.H.; Barrak, O.S.; Al-Adili, A.S.; Hussein, S.K.; Hussein, A.K. Study the effect of filer material on microstructure of welding the carbon steel in shielded metal arc welding. J. Mech. Eng. Res. Dev. 2020, 43, 408–416. [Google Scholar]
- Ahmad, M.; Arifin, A.; Abdullah, S.; Jusoh, W.; Singh, S. Fatigue crack effect on magnetic flux leakage for A283 grade C steel. Steel Compos. Struct. 2015, 19, 1549–1560. [Google Scholar] [CrossRef]
- Liu, H.; Chen, C.; Yuan, X.; Tan, Y.; Meng, G.; Liu, H.; Cheng, Y.F. Corrosion inhibition behavior of X80 pipeline steel by imidazoline derivative in the CO2-saturated seawater containing sulfate-reducing bacteria with organic carbon starvation. Corros. Sci. 2022, 203, 110345. [Google Scholar] [CrossRef]
- Marais, T.S.; Huddy, R.J.; Van Hille, R.P.; Harrison, S.T.L. Effect of temperature change on the performance of the hybrid linear flow channel reactor and its implications on sulphate-reducing and sulphide-oxidising microbial community dynamics. Front. Bioeng. Biotechnol. 2022, 10, 908463. [Google Scholar] [CrossRef] [PubMed]
- Tanner, R.S. Monitoring sulfate-reducing bacteria: Comparison of enumeration media. J. Microbiol. Methods 1989, 10, 83–90. [Google Scholar] [CrossRef]
- Green, A.A. The Preparation of Acetate and Phosphate Buffer Solutions of Known PH and Ionic Strength. J. Am. Chem. Soc. 1933, 55, 2331–2336. [Google Scholar] [CrossRef]
- Lynch, T.P.; Bihl, D.E.; Johnson, M.; Maclellan, J.A.; Piper, R.K. Hanford Radiological Protection Support Services Annual Report for 2000; Pacific Northwest National Lab. (PNNL): Richland, WA, USA, 2001. [Google Scholar] [CrossRef]
- Missoum, A. Methods for Isolation and Identification of Microorganisms. In Microbial Systematics: Taxonomy, Microbial Ecology, Diversity; CRC Press: Boca Raton, FL, USA, 2020; pp. 28–50. [Google Scholar] [CrossRef]
- Anita, N.; Joany, R.M.; Dorothy, R.; Aslam, J.; Rajendran, S.; Subramania, A.; Singh, G.; Verma, C. Linear polarization resistance (LPR) technique for corrosion measurements. In Electrochemical and Analytical Techniques for Sustainable Corrosion Monitoring; Elsevier: Amsterdam, The Netherlands, 2023; pp. 59–80. [Google Scholar]
- Adnan, M.A.; Kee, K.-E.; Raja, P.B.; Ismail, M.C.; Kakooei, S. Influence of Heat Treatment on the Corrosion of Carbon Steel in Environment Containing Carbon Dioxide and Acetic Acid. IOP Conf. Ser. Mater. Sci. Eng. 2018, 370, 012039. [Google Scholar] [CrossRef]
- Badea, G.E.; Caraban, A.; Sebesan, M.; Dzitac, S.; Cret, P.; Setel, A. Polarisation measurements used for corrosion rates determination. J. Sustenable Energy 2010, 1, 1–4. [Google Scholar]
- Angst, U.; Büchler, M. A new perspective on measuring the corrosion rate of localized corrosion. Mater. Corros. 2020, 71, 808–823. [Google Scholar] [CrossRef]
- Crozier, B.; Been, J.; Tsaprailis, H.; Place, T.D. Long term evaluation of microbial induced corrosion contribution to underdeposit sludge corrosivity in a heavy crude oil pipeline. In CORROSION 2013; OnePetro: Richardson, TX, USA, 2013. [Google Scholar]
- Zhao, R.; Wang, B.; Li, D.; Chen, Y.; Zhang, Q. Effect of sulfate-reducing bacteria from salt scale of water flooding pipeline on corrosion behavior of X80 steel. Eng. Fail. Anal. 2022, 142, 106788. [Google Scholar] [CrossRef]
- Pourmadadi, M.; Mirshafiei, M.; Yazdian, F.; Rasekh, B.; Zamani, M.; Mansouri, A.; Rahdar, A.; Pandey, S. A study on the microbial biocorrosion behavior of API 5 L X65 carbon steel exposed to seawater. Environ. Prog. Sustain. Energy 2023, e14210. [Google Scholar] [CrossRef]
- Kahyarian, A.; Schumaker, A.; Brown, B.; Nesic, S. Acidic corrosion of mild steel in the presence of acetic acid: Mechanism and prediction. Electrochim. Acta 2017, 258, 639–652. [Google Scholar] [CrossRef]
- Hedges, B.; McVeigh, L. The role of acetate in CO2 corrosion: The double whammy. In CORROSION 1999; OnePetro: Richardson, TX, USA, 1999. [Google Scholar]
- Davis, J. Introduction to Surface Engineering for Corrosion and Wear Resistance; ASM International: Detroit, MI, USA, 2001; pp. 1–10. [Google Scholar] [CrossRef]

| Element | C | Si | Mn | P | S | Cu (min) |
|---|---|---|---|---|---|---|
| Content (%) | 0.24 | 0.15–0.40 | 0.90 | 0.035 | 0.04 | 0.20 |
| Material | Yield Strength ksi (Mpa) | Tensile Strength ksi (Mpa) | Elongation 8 Inch | Elongation 2 Inch |
|---|---|---|---|---|
| A283 Grade C | 30 (205) | 55–75 (380–515) | 22 | 25 |
| Parameters | Descriptions |
|---|---|
| Working electrode | Carbon steel A283 Grade C |
| Duration | 42 days |
| Size of sample | 10 mm × 10 mm × 5 mm |
| Pressure | Atmospheric pressure (constant) |
| Temperature (°C) | 25 |
| Solutions for Case A | Test-1A: 3% NaCl with CO2 |
| Test-2A: 3% NaCl + 1500 ppm acetate with CO2 | |
| Test-3A: 3% NaCl + SRB with CO2 | |
| Test-4A: 3% NaCl + 1500 ppm acetate + SRB with CO2 | |
| Solutions for Case B | Test-1B: PMB + 3% NaCl with CO2 |
| Test-2B: PMB + 3% NaCl + 1500 ppm acetate with CO2 | |
| Test-3B: PMB + 3% NaCl + SRB with CO2 | |
| Test-4B: PMB + 3% NaCl + 1500 ppm acetate + SRB with CO2 | |
| Sample type (working electrode) | The surface was finished with SiC paper with grits of 80, 120, 240, 320, 400, and 600. |
| Weight (g) | Test-1A | Test-2A | Test-3A | Test-4A |
|---|---|---|---|---|
| Before | 4.58 (±0.05) | 4.45 (±0.03) | 4.67 (±0.03) | 4.86 (±0.01) |
| After | 4.21 (±0.05) | 4.21 (±0.05) | 4.21 (±0.04) | 4.31 (±0.03) |
| Weight loss | 0.37 (±0.02) | 0.23 (±0.04) | 0.45 (±0.04) | 0.54 (±0.02) |
| Corrosion rate (mm/year) | 0.83 (±0.04) | 0.52 (±0.05) | 1.01 (±0.02) | 1.20 (±0.05) |
| Weight (g) | Test-1B | Test-2B | Test-3B | Test-4B |
|---|---|---|---|---|
| Before | 4.70 (±0.05) | 4.76 (±0.03) | 4.99 (±0.03) | 4.65 (±0.01) |
| After | 4.36 (±0.05) | 4.52 (±0.05) | 4.48 (±0.04) | 4.05 (±0.03) |
| Weight loss | 0.33 (±0.02) | 0.23 (±0.03) | 0.50 (±0.04) | 0.59 (±0.02) |
| Corrosion rate (mm/year) | 0.74 (±0.04) | 0.51 (±0.05) | 1.12 (±0.02) | 1.32 (±0.05) |
Disclaimer/Publisher’s Note: The statements, opinions and data contained in all publications are solely those of the individual author(s) and contributor(s) and not of MDPI and/or the editor(s). MDPI and/or the editor(s) disclaim responsibility for any injury to people or property resulting from any ideas, methods, instructions or products referred to in the content. |
© 2023 by the authors. Licensee MDPI, Basel, Switzerland. This article is an open access article distributed under the terms and conditions of the Creative Commons Attribution (CC BY) license (https://creativecommons.org/licenses/by/4.0/).
Share and Cite
Ismail, M.R.; Ismail, M.C.; Shah, S.Z.H. Effect of Acetate on Microbiologically Influenced Corrosion of Internal Pipeline Surfaces. Metals 2023, 13, 1974. https://doi.org/10.3390/met13121974
Ismail MR, Ismail MC, Shah SZH. Effect of Acetate on Microbiologically Influenced Corrosion of Internal Pipeline Surfaces. Metals. 2023; 13(12):1974. https://doi.org/10.3390/met13121974
Chicago/Turabian StyleIsmail, Mohamed Riyadh, Mokhtar Che Ismail, and Syed Zulfiqar Hussain Shah. 2023. "Effect of Acetate on Microbiologically Influenced Corrosion of Internal Pipeline Surfaces" Metals 13, no. 12: 1974. https://doi.org/10.3390/met13121974
APA StyleIsmail, M. R., Ismail, M. C., & Shah, S. Z. H. (2023). Effect of Acetate on Microbiologically Influenced Corrosion of Internal Pipeline Surfaces. Metals, 13(12), 1974. https://doi.org/10.3390/met13121974





